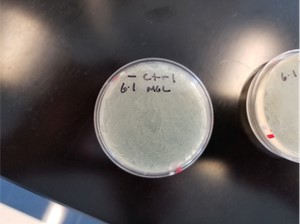
不含羧苄青霉素的对照组平板
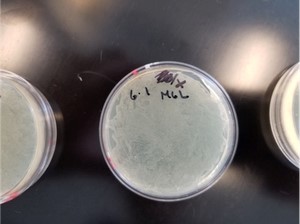
0.1 mg/mL 的羧苄青霉素溶液涂布于琼脂平板
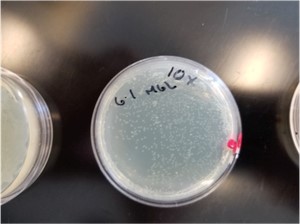
1 mg/mL 的羧苄青霉素平板
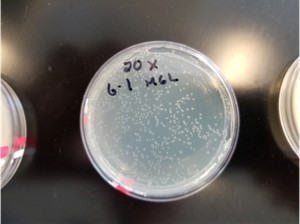
羧苄青霉素溶液涂布于琼脂平板
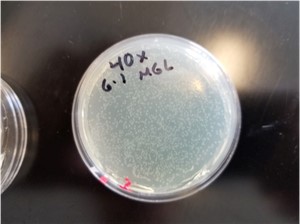
羧苄青霉素溶液涂布于琼脂平板

分子实验笔记08:琼脂表面加抗生素法(Over-Agar Antibiotic Plating)
来源:武汉市灰藻生物科技有限公司 浏览量:28 发布时间:2026-03-10 14:06:41
引言(Introduction)
本方案描述了一种在已凝固的LB琼脂平板表面添加抗生素的方法,用于筛选转化成功的大肠杆菌(E. coli)。
该“琼脂表面加药”(over-agar plating)技术的优势在于:研究者无需为不同抗性基因的质粒,分别配制含抗生素的琼脂平板,即可在同一基础平板上,灵活筛选携带不同抗性标记的转化子。
本方案以羧苄青霉素(carbenicillin)为例进行说明,但该方法可推广至其他抗生素——只需通过预实验绘制选择曲线(selection curve),确定最佳工作浓度即可。
设备(Equipment)
- 用于移液和涂布的枪头(Pipette tips for both pipetting and spreading)
- 本生灯或其他小型火焰源(Bunsen burner or other small flame source)
- 恒温培养箱(Incubator)
试剂(Reagents)
- 不含抗生素的6 cm直径LB/琼脂平板(6 cm diameter LB/agar plates without antibiotic)
- 高浓度(100 mg/mL,即1000×)羧苄青霉素母液(溶于无菌水;也可替换为其他抗生素)
- 已转化含羧苄青霉素(或相应抗生素抗性基因)的E. coli菌株
操作步骤(Procedure)
第一天(Day 1)
1. 将羧苄青霉素用LB液体培养基稀释至1–4 mg/mL的工作浓度。
- 该浓度范围是通过经验确定的,可实现有效的表面选择(参见下方选择曲线)。
- 此处选用羧苄青霉素(carbenicillin)而非氨苄青霉素(ampicillin),因其化学性质更稳定,能更有效地抑制非转化菌生长(例如显著减少“卫星菌落” satellite colonies 的出现),尽管成本更高。
- 2. 在已凝固的6 cm LB-琼脂平板上,加入150 µL上述羧苄青霉素溶液,并轻柔涂布至整个表面,直至液体基本被吸收(表面仅残留极少量可见液滴)。
- 我们通常直接使用移液枪头进行涂布:将枪头轻轻弯折成“L”形,即可作为简易涂布棒。也可使用其他适配培养皿尺寸的无菌涂布工具。
- 3. 盖上皿盖,在室温下静置至少30分钟,使抗生素充分渗入琼脂表层。
- 4. 在此期间,通过热激法(heat shock)将目标质粒转化入DH5α E. coli感受态细胞。
- 5. 取50 µL转化后的菌液(含复苏培养基),滴加至已加抗生素的平板上,并轻柔涂布至液体基本吸收。
- 涂布方式同上,可使用弯折的枪头或其他适配的涂布器。
- 6. 将平板倒置于37°C培养箱中,培养18小时。
第二天(Day 2)
7. 观察菌落形成情况。
以下展示了优化羧苄青霉素浓度用于E. coli转化子筛选的实验结果。
示例数据(Sample Data)
在LB-琼脂平板上,通过琼脂表面添加不同浓度羧苄青霉素筛选转化E. coli的结果:
图1:不含羧苄青霉素的对照组平板
- 对照组(无羧苄青霉素):
平板呈菌苔(lawn),无选择效果。
图2:将 150 µL 浓度为 0.1 mg/mL 的羧苄青霉素溶液涂布于琼脂平板上
- 150 µL 0.1 mg/mL 羧苄青霉素:
仍呈菌苔,未见明显选择作用。
图3:将 150 µL 浓度为 1 mg/mL 的羧苄青霉素溶液涂布于琼脂平板上
- 150 µL 1 mg/mL 羧苄青霉素:
出现多个清晰、分离的单菌落,选择效果良好。
图4:将 150 µL 浓度为 2 mg/mL 的羧苄青霉素溶液涂布于琼脂平板上
- 150 µL 2 mg/mL 羧苄青霉素:
菌落数量少于1 mg/mL组,但仍为有效选择。
图5:将 150 µL 浓度为 4 mg/mL 的羧苄青霉素溶液涂布于琼脂平板上
- 150 µL 4 mg/mL 羧苄青霉素:
菌落数量与1–2 mg/mL组相当,但菌落尺寸明显更小,表明高浓度可能轻微抑制细菌生长,但仍具备有效选择能力。 
- 图6:转化大肠杆菌经羧苄青霉素琼脂平板铺板后的选择曲线图:羧苄青霉素琼脂表面加药后转化E. coli的选择曲线。图中所示为每板加入150 µL不同浓度母液的结果。
注:我们发现该方法对多种抗生素浓度具有较宽的耐受范围,上述结果仅代表单次实验。若用于发表数据,需重复实验以评估变异性。
参考文献
https://www.addgene.org/
敬请关注灰藻生物,共筑健康未来!
— 武汉市灰藻生物科技有限公司团队敬上
灰藻生物:我们期待着与客户共同成长,共创生命科学的美好未来!
更新日期:2026-02-28
编制人:磊子
审稿人:小藻